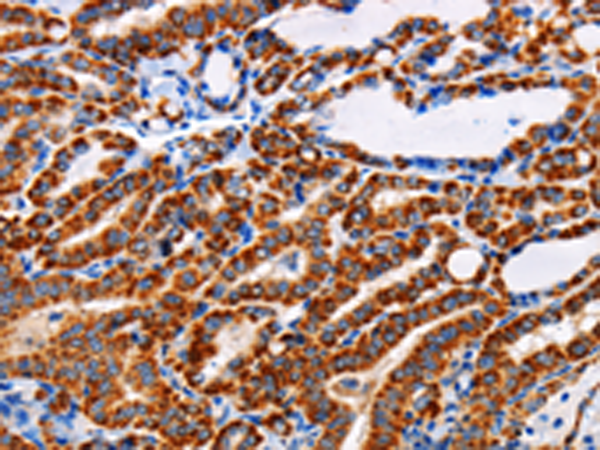
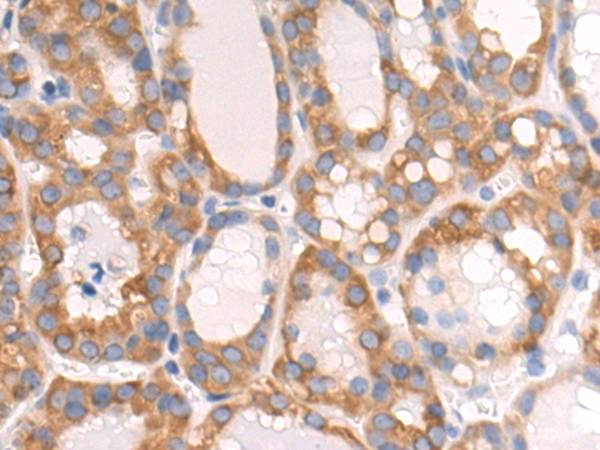
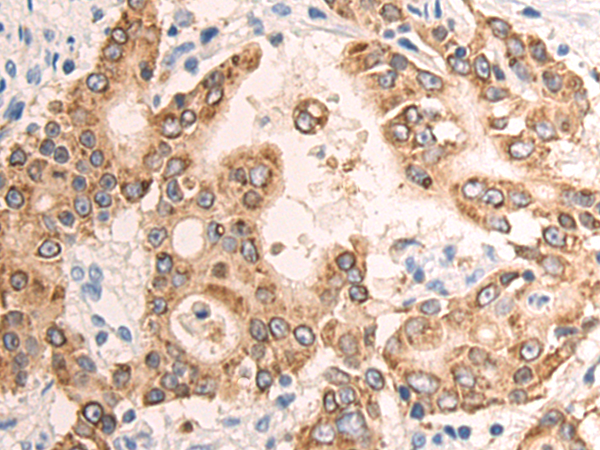
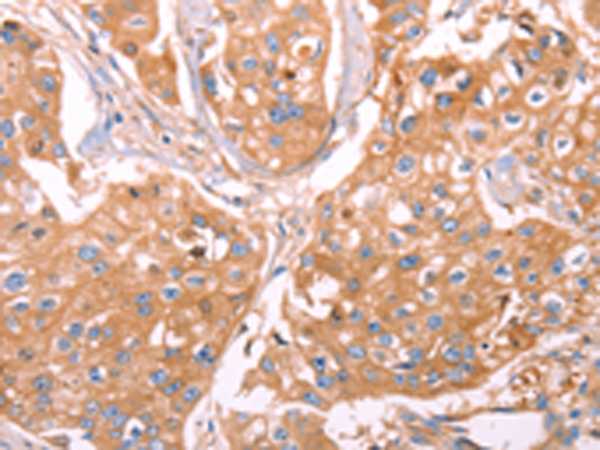
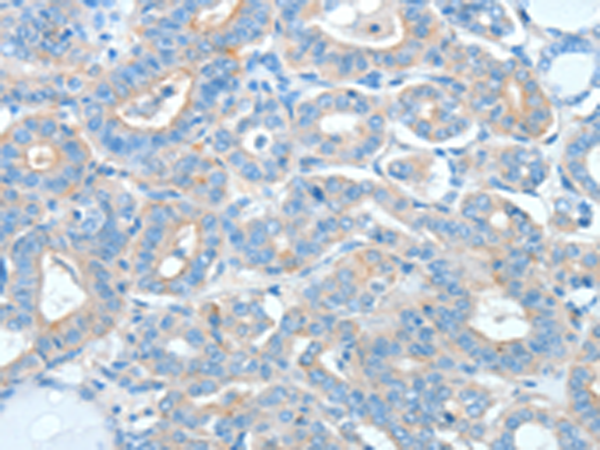

-
分类: 科研抗体货号: P00813别名: LABH1应用: IHC反应种属: Human
-
分类: 科研抗体货号: P00883别名: ADH1应用: IHC反应种属: Human
-
分类: 科研抗体货号: P00798别名:应用: WB反应种属: Human
-
分类: 科研抗体货号: P00882别名: ASB; ANH1; XLSA; ALASE; XLDPP; XLEPP; ALAS-E应用: WB反应种属: Human, Mouse, Rat
-
分类: 科研抗体货号: P00796别名: SCAND4; HUCEP-4; dJ874C20.4应用: IHC反应种属: Human
-
分类: 科研抗体货号: P00872别名: AG3; AG-3; HAG3; hAG-3; BCMP11; PDIA18应用: WB,IHC反应种属: Human, Mouse
-
分类: 科研抗体货号: P00795别名: SUFUH; JBTS32; SUFUXL; PRO1280应用: WB反应种属: Human, Mouse
-
分类: 科研抗体货号: P00871别名: 1-AGPAT4; dJ473J16.2; LPAAT-delta; RP3-473J16.2应用: IHC反应种属: Human, Mouse, Rat
-
分类: 科研抗体货号: P00791别名: DBP; GRD3; VDBG; VDBP; DBP/GC应用: WB,IHC反应种属: Human
-
分类: 科研抗体货号: P00870别名: Q10; EIF2C2应用: IHC反应种属: Human, Mouse, Rat

鄂公网安备42018502007531号
鄂公网安备42018502007531号

